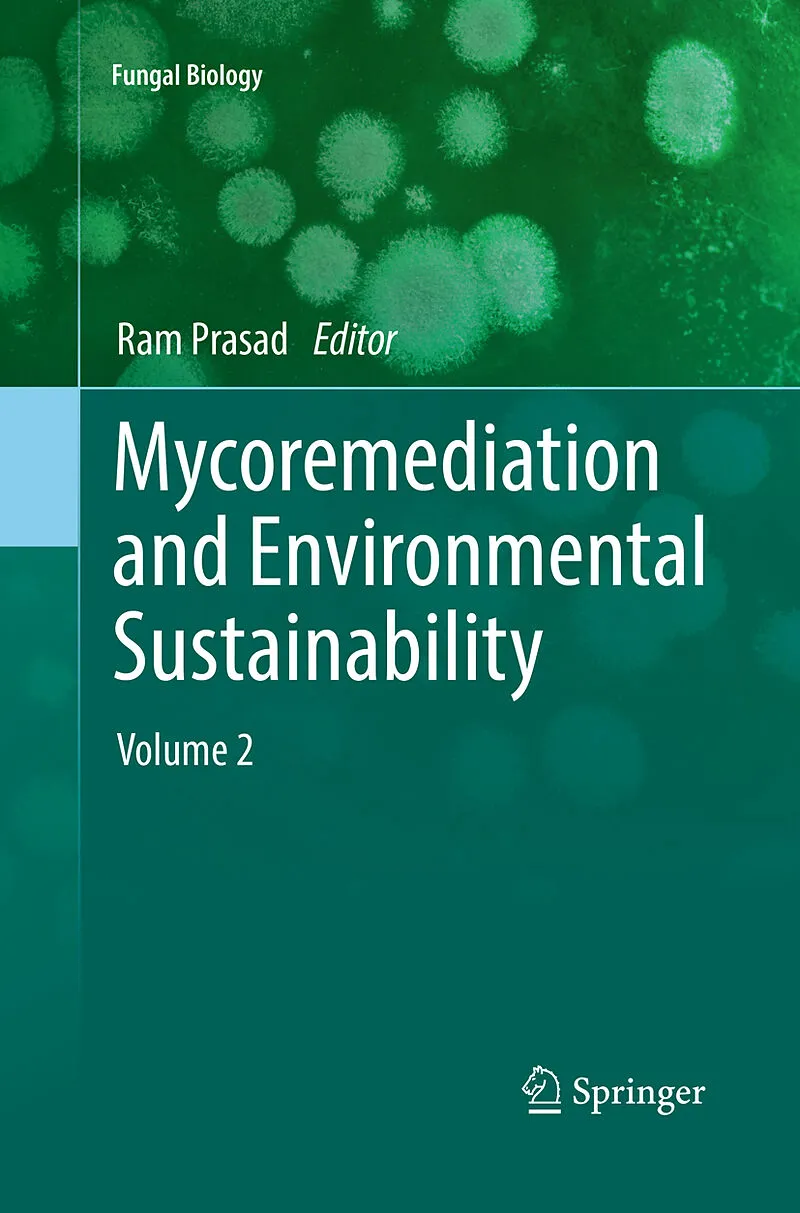

Beschreibung
Bioremediation is the use of microorganisms' metabolism to degrade waste contaminants (sewage, domestic, and industrial effluents) into non-toxic or less toxic materials by natural biological processes. Volume 2 offers new discussion of remediation through fun...Bioremediation is the use of microorganisms' metabolism to degrade waste contaminants (sewage, domestic, and industrial effluents) into non-toxic or less toxic materials by natural biological processes. Volume 2 offers new discussion of remediation through fungior mycoremediationand its multifarious possibilities in applied remediation engineering and the future of environmental sustainability. Fungi have the biochemical and ecological capability to degrade environmental organic chemicals and to decrease the risk associated with metals, semi-metals, noble metals, and radionuclides, either by chemical modification or by manipulating chemical bioavailability. Additional expanded texts shows the capability of these fungi to form extended mycelia networks, the low specificity of their catabolic enzymes, and their use against pollutants as a growth substrate, making these fungi well suited for bioremediation processes. Their mycelia exhibit the robustness of adapting to highly limiting environmental conditions often experienced in the presence of persistent pollutants, which makes them more useful compared to other microbes. Despite dominating the living biomass in soil and being abundant in aquatic ecosystems, however, fungi have not been exploited for the bioremediation of such environments until this added Volume 2. This book covers the various types of fungi and associated fungal processes used to clean up waste and wastewaters in contaminated environments and discusses future potential applications.
Expanded discussion of fungal applications for environmental sustainability Volume 2 includes approaches to fertilization, decolorization, and discussion of marine fungi Offers additional discussion of fungal solutions for waste from agriculture, wineries, mills, and other industries
Autorentext
Ram Prasad is Assistant Professor at the Amity Institute of Microbial Technology, Amity University, Uttar Pradesh, India. Dr. Prasad completed his Ph.D. at the Department of Microbiology, Chaudhary Charan Singh University, Meerut, UP, India, in collaboration with School of Life Sciences, Jawaharlal Nehru University (JNU), New Delhi, India. He received his M.Sc. in Life Sciences at JNU and also qualified CSIR-NET, ASRB-NET, and GATE. His research interest includes plant microbe-interactions, sustainable agriculture and microbial nanobiotechnology. Dr. Prasad has ninety five publications to his credit, including research papers & book chapters and five patents issued or pending, and edited or authored several books. Dr. Prasad has eleven years of teaching experience and he has been awarded the Young Scientist Award (2007) and Prof. J.S. Datta Munshi Gold Medal (2009) by the International Society for Ecological Communications; FSAB fellowship (2010) by the Society for Applied Biotechnology; Outstanding Scientist Award (2015) in the field of Microbiology by Venus International Foundation; and the American Cancer Society UICC International Fellowship for Beginning Investigators (USA, 2014). In 2014-2015, Dr. Prasad served as Visiting Assistant Professor in the Department of Mechanical Engineering at Johns Hopkins University, USA.
Inhalt
Preface.- Bioremediation Applications with Fungi.- Role of Phytochelatines (PCs), Metallothionines (MTs) and Heavy metal ATPase (HMA) Genes in Heavy Metal Tolerance.- Production of Biooils from Microbial Biomasses.- Mycoremediation of Agricultural soil: Bioprospection for sustainable development.- Bioremediation and Decolorization of Textile Dyes by White Rot Fungi and Laccase Enzymes.- Mycoremediation of Common Agricultural Pesticides.- Bioremediation of Insecticides by White Rot Fungi and its Environmental Relevance.- An Overview of Fungal Applications in the Valorization of Lignocelullosic Agricultural By-products: The case of Two-phase Olive Mill Wastes.- Fungal Conversion and Valorization of Winery Wastes.- Biosorption of Dye and Heavy Metal Pollutants by Fungal Biomass: A Sustainable Approach.- Application of Myconanotechnology in the Sustainable Management of Crop Production System.- Obligate Marine Fungi and Bioremediation.- Mycoremediation Mechanisms for Heavy Metal Resistance/Tolerance in Plants.- Fungal Derived Chitosan Based Nanocomposites: A Sustainable Approach for Heavy Metal Biosorption and Environmental Management.- Index.-
